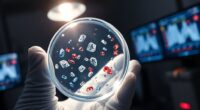
microplastic pollution solutions 2025

To master composting at home, focus on balancing green materials like veggie scraps with brown materials such as leaves or shredded paper. Keep your compost moist—like a wrung-out sponge—and turn it regularly to add oxygen, which speeds up decomposition and prevents odors. Proper placement and monitoring temperature help maintain microbial activity, resulting in rich soil. With some simple tips, you’ll turn waste into garden gold—stick around to discover more ways to optimize your composting journey.
Key Takeaways
- Choose a suitable, protected location for your compost bin to ensure easy access and proper weather protection.
- Balance green nitrogen-rich materials with brown carbon-rich materials for efficient decomposition and healthy microbial activity.
- Regularly turn the compost to aerate and maintain oxygen levels, preventing odors and speeding up decomposition.
- Keep moisture levels damp like a wrung-out sponge, adjusting with water or dry materials as needed.
- Monitor compost temperature to gauge microbial activity and turn the pile when the temperature drops.

Have you ever wondered how to turn everyday kitchen scraps and yard waste into rich, healthy soil? Composting is a simple way to do just that, and it can transform your garden and reduce waste at the same time. To get started, understanding soil health is essential. Healthy soil isn’t just about nutrients; it also depends on good structure, aeration, and moisture levels. Compost improves all these factors by adding organic matter that feeds beneficial microbes, fungi, and earthworms. When you maintain your compost bin properly, it stays active and productive, ensuring your compost develops the right balance of materials.
Proper compost bin maintenance involves a few key steps. First, you need to keep the bin in a location that’s accessible but not exposed to extreme weather. Regularly turning the compost is vital because it aerates the pile, providing oxygen that microbes need to break down organic matter efficiently. This process speeds up decomposition and prevents foul odors, which often result from anaerobic conditions. When maintaining your compost bin, monitor moisture levels. The compost should be as damp as a wrung-out sponge—not too wet, to avoid creating a soggy mess, and not too dry, which stalls microbial activity. If it gets dry, add a bit of water; if it’s too wet, turn the pile and add dry, carbon-rich materials like straw or shredded paper to absorb excess moisture.
Balancing green and brown materials is another critical aspect of compost bin maintenance. Greens, such as vegetable scraps and grass clippings, provide nitrogen, while browns, like leaves and cardboard, supply carbon. Maintaining this balance helps keep the compost rich in nutrients and promotes healthy microbial activity. Be mindful of what goes in—avoid meat, dairy, or oily foods, which can attract pests and create odor problems. Regularly checking your compost’s temperature can also guide your maintenance routine. A hot compost pile indicates active decomposition, which means your microbes are thriving. If the temperature drops, turn the pile to reintroduce oxygen and stir things up. Additionally, using a high-quality projector can enhance the visual aspect of your gardening space, making it more enjoyable to check on your composting progress.

Utopia Kitchen Countertop Compost Bin Kitchen with Charcoal Filter -1.3gallon Stainless Steel Kitchen Compost Bin Countertop – Ideal Kitchen Essentials or Small Composter for Under The Sink Trash
This Counter Compost Bin With Lid Having Capacity Of 1.3 Gallon Is Manufactured With Stainless Steel For Optimal…
As an affiliate, we earn on qualifying purchases.
As an affiliate, we earn on qualifying purchases.
Frequently Asked Questions
How Long Does It Typically Take for Compost to Be Ready?
It usually takes about 3 to 6 months for compost to be ready. To speed up the process, you should regularly turn your compost, which aerates it and promotes decomposition. Also, maintaining proper moisture control—keeping it damp but not soaked—helps microbes break down materials faster. Consistent compost turning and moisture management are key to producing rich, usable compost within this timeframe.
Can I Compost Cooked Food Scraps or Meat?
Sure, you can compost cooked food scraps and meat, but it’s a bit of a culinary rebellion. Cooked food considerations mean they attract pests and slow down the process. Meat composting tips include burying scraps deep, balancing with carbon-rich materials, and avoiding excess. Ironically, while it’s tempting to toss everything in, sticking to plant-based scraps guarantees your compost remains healthy and odor-free.
What Are Common Pests Attracted to Compost Bins?
Common pests like flies, rats, and ants are attracted to compost bins, especially if you don’t practice pest prevention or proper bin maintenance. To keep them away, turn your compost regularly, ensure it’s covered, and avoid adding meat or cooked food scraps. Proper pest prevention and consistent bin maintenance help keep pests at bay, maintaining a healthy, odor-free compost that benefits your garden without attracting unwanted visitors.
How Do I Troubleshoot a Foul Odor Coming From My Compost?
If your compost smells foul, start by improving odor control. Turn the bin regularly to aerate it, which helps release built-up gases. Guarantee proper bin ventilation by adding ventilation holes or using a well-ventilated bin. Avoid adding too much wet or greasy material, as this causes odors. Balancing greens and browns also helps, so layer your compost correctly. These steps will reduce odors and keep your compost healthy.
Is Composting Suitable for Small Apartment Spaces?
Did you know 50% of households generate food waste that could be composted? Absolutely, apartment composting is suitable for small spaces if you use small space solutions like countertop bins or worm bins. You’ll find it easy to manage and environmentally friendly. Just guarantee good airflow and regular maintenance. With a little effort, you can turn kitchen scraps into nutrient-rich compost right in your apartment!

EPICA Countertop Compost Bin Kitchen | 1.3 Gallon | Odorless Composting Bin with Carbon Filters | Indoor Compost Bin with Lid | Stainless Steel Kitchen Composter for Food Scraps & Waste Recycling
FEATURED IN BON APPETIT & FORBES: Recognized by renowned magazines, EPICA’s compost bin is a perfectly sized marvel…
As an affiliate, we earn on qualifying purchases.
As an affiliate, we earn on qualifying purchases.
Conclusion
Now that you’ve got the basics down, you’re ready to turn your kitchen scraps into gold—literally! Composting at home isn’t just good for the planet; it’s like holding a secret superpower that transforms waste into rich, life-giving soil. Keep patience and practice, and soon you’ll be a composting master, creating nutrient-packed earth that’ll make your garden flourish like never before. Get ready to watch your garden thrive—your composting skills are about to change everything!

Reotemp 20 Inch Fahrenheit Backyard Compost Thermometer with Digital Composting Guide
Perfect for the Beginner Composter – Free PDF Digital Compost Guide Included – Expert instructions on how to…
As an affiliate, we earn on qualifying purchases.
As an affiliate, we earn on qualifying purchases.

EJWOX Stainless Steel Compost Aerator Tool – Manual Turner & Mixer for Compost Tumblers and Bins | Faster Decomposition, Rust-Proof
Speed Your Compost Pile – Using this compost starter can add air to your bin full of grass…
As an affiliate, we earn on qualifying purchases.
As an affiliate, we earn on qualifying purchases.